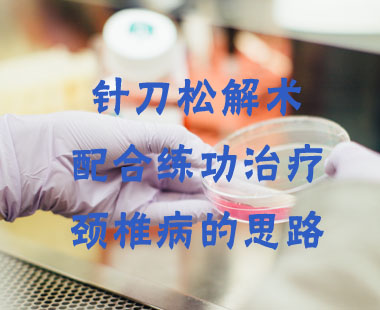

主讲: 王文生 分类:临床教学 课时:3 发布时间:2019/06/04
简介: 本期节目是由北京大学第一医院王文生主讲的慢性粒单核细胞白血病(CMML)诊治进展,它是起源于造血干细胞的恶性疾病,兼具MPN及MDS特征,典型特征为外周血单核细胞增多、骨髓增生异常、血细胞减少及肝脾肿大。讲述了慢性粒单核细胞白血病的发病机制,病因病理,以及它的临床表现和有效治疗方法。

主讲: 赵俊英 分类:临床教学 课时:2 发布时间:2019/06/04
简介: 本期节目是由北京市皮肤病专家会诊中心主任赵俊英主讲的皮肤真菌病,由真菌引起的皮肤疾病叫皮肤真菌病(浅部真菌病),主要侵犯表皮、毛发、甲板。根据感染部位的不同,可分为头癣、体癣、股癣、手足癣、甲癣及花斑癣等。主要介绍了各种真菌病的临床表现及辅助检查,诊断及治疗方法。

主讲: 赵俊英 分类:临床教学 课时:2 发布时间:2019/06/04
简介: 本期节目是由北京市皮肤病专家会诊中心主任赵俊英主讲的药疹,主要是指药物通过内服、注射、使用栓剂、灌肠或吸入及经破损皮肤等途径进入人体,在皮肤黏膜上引起的炎症皮损称为药疹。药物反应的原因和机理非常复杂,除药物本身因素外,还包括滥用、错用、过大剂量、同时服用多种药物等等。接着讲述了发病机制免疫性反应和临床表现等等,还讲述了药疹的种类和对应的治疗方法。

主讲: 王美芳 分类:临床教学 课时:2 发布时间:2019/06/04
简介: 本期节目是由首都医科大学附属北京友谊医院王美芳主讲的荨麻疹的诊治,首先讲述了荨麻疹是由于皮肤、黏膜小血管扩张及渗透性增加出现的一种局限性水肿反应。接着讲述了荨麻疹和血管性水肿的临床表现,以及荨麻疹的发病病因,包括外源性病因和内源性病因,荨麻疹分类是正确诊断的第一步,包括自发性和诱导性的。最后讲述了荨麻疹的诊断以及有效治疗方法。

主讲: 王美芳 分类:临床教学 课时:2 发布时间:2019/06/04
简介: 本期节目是由首都医科大学附属北京友谊医院王美芳主讲的带状疱疹的诊疗,首先讲了带状疱疹是由水痘—带状疱疹病毒引起的感染性皮肤病。接着讲了带状疱疹的流行病学,发病机制,临床表现及好发部位,带状疱疹特殊和典型的临床表现,带状疱疹的诊断,最后主要讲述了带状疱疹的治疗,治疗的一些抗病毒药物,以及如何预防带状疱疹的高发。

主讲: 雒东江 分类:临床教学 课时:2 发布时间:2019/06/04
简介: 本期节目是由北京航天总医院雒东江主讲的后循环缺血的评估和介入治疗,它包含了四个方面的内容:第一后循环缺血性脑卒中的定义,第二循环缺血性脑卒中的特点,第三后循环缺血的介入治疗,第四后循环介入治疗存在的问题。详情敬请收看。

主讲: 贾伟华 分类:临床教学 课时:2 发布时间:2019/06/04
简介: 本期节目是由首都医科大学附属北京朝阳医院神经内科主任贾伟华主讲的颈动脉粥样硬化分层处理和挑战,包含了四个方面的内容:第一经动脉粥样硬化的流行病学资料,第二症状颈动脉狭窄的管理,第三无症状颈动脉狭窄的管理,第四颈动脉不稳定斑块的识别和处理。详情敬请收看。

主讲: 付睿 分类:临床教学 课时:1 发布时间:2019/06/04
简介: 本期节目是由首都医科大学附属北京世纪坛医院神经内科副主任付睿主讲的急性缺血性卒中介入治疗的基础和相关技术,主要从四个方面进行了讲解,第一急性缺血性卒中介入治疗的依据;第二急性缺血性卒中介入治疗的研究现状;第三急性缺血性卒中介入治疗术中和术后的监护及处理;第四急性缺血性卒中介入治疗的并发症及处理。

主讲: 付睿 分类:临床教学 课时:1 发布时间:2019/06/04
简介: 本期节目是由首都医科大学附属北京世纪坛医院神经内科副主任付睿主讲的静脉和动脉联合溶栓治疗急性缺血性脑卒中,包含了三个方面的内容,第一静脉和动脉联合溶栓的研究现状,第二静脉和动脉联合溶栓病例,第三静脉和动脉联合溶栓治疗存在的问题。
主讲: 赵立军 分类:临床教学 课时:3 发布时间:2019/06/04
简介: 本期节目是由北京市宣武中医医院骨伤科专家赵立军主讲的针刀松解术配合练功治疗颈椎病的思路,内容包含四个方面:第一介绍了颈椎病的基础知识,包括颈椎病的概念、颈椎病的好发因素、颈椎的解剖特点、颈椎病的分型等等。第二科学选取运动处方改善颈椎曲度,包括“牵引”以及气功疗法在治疗颈椎病上的优势,第三针刀疗法治疗颈椎病,包括治疗原理以及针刀疗法操作步骤。第四健康宣教。